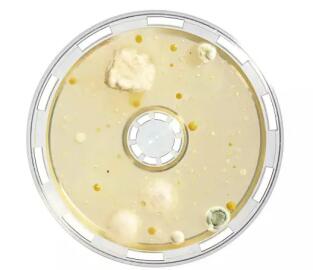

目前,隨著生物科技的發展,病毒的種類也在不斷更新,一系列新型病毒通過空氣等媒介快速傳播,可引起人類及動物的多種嚴重疾病。
由于病毒是一類不具細胞結構,具有遺傳、復制等生命特征的微生物,其大小小于細菌,故空氣中的病毒采集難度大于細菌,采集過程中的截留率也值得關注。
帝博思提供一種適用于截留病毒的產品(TIPS800),為檢測環境中的病毒提供多種解決方案。

水溶膜是一種采用明膠制成的濾膜,可溶于水。標稱孔徑3μm,區別于普通的3μm濾膜,水溶膜厚度為250μm,是普通纖維素類濾膜的兩倍以上,電鏡下可見疏松多孔結構,屬于深層過濾,可以有效截留粒徑較小的微生物。經檢測,對T3病毒具有99.94%的截留率。

使用便攜式浮游菌/病毒采樣儀,搭配單層無菌包裝水溶膜采樣頭,通過設置合適的流速與采樣體積,對空氣中的病毒進行截留。采樣結束后使用緩沖液溶解水溶膜,收集樣品中的病毒,并進行下一步處理。

您是否也有這樣的煩惱?
● 難以尋找到合適的病毒采集方法
● 截留病毒后處理步驟復雜
● 對設備的病毒截留率表示懷疑
● 尋求輕便易攜帶的裝置進行采樣

水溶膜基于其獨特的材質與結構,對微生物具有高截留率,并且水溶膜的含水性有利于維持所收集微生物的存活,從而提供長達8小時的連續采樣時間。

水溶膜在全球諸多領域都得到成功的應用,包括了:在流感爆發時期,進行流感病毒采樣與檢測;在航空航天領域進行特殊區域的空氣采樣;在霧霾等極端空氣環境下進行病毒采樣與分析;在養殖廠進行特殊致病菌的采樣……
經驗證水溶膜可有效截留病毒,保證采樣效率及成功率。
水溶膜使樣品的后處理方式選擇性更多,可以滿足不同領域對于檢測空氣中病毒的應用需求。
多種無菌包裝的水溶膜可供選擇,無二次污染風險,應用方式靈活。
便攜式可充電采樣器,適用于不同環境情況。
該產品主要應用領域:各大疾控中心,醫院ICU,環境監測,微生物質控,檢驗檢疫部門。現在誠邀全國各區域實力經銷商共同合作。
歡迎來電咨詢:嚴經理 13816550546 021-61905014 13816550546@163.com